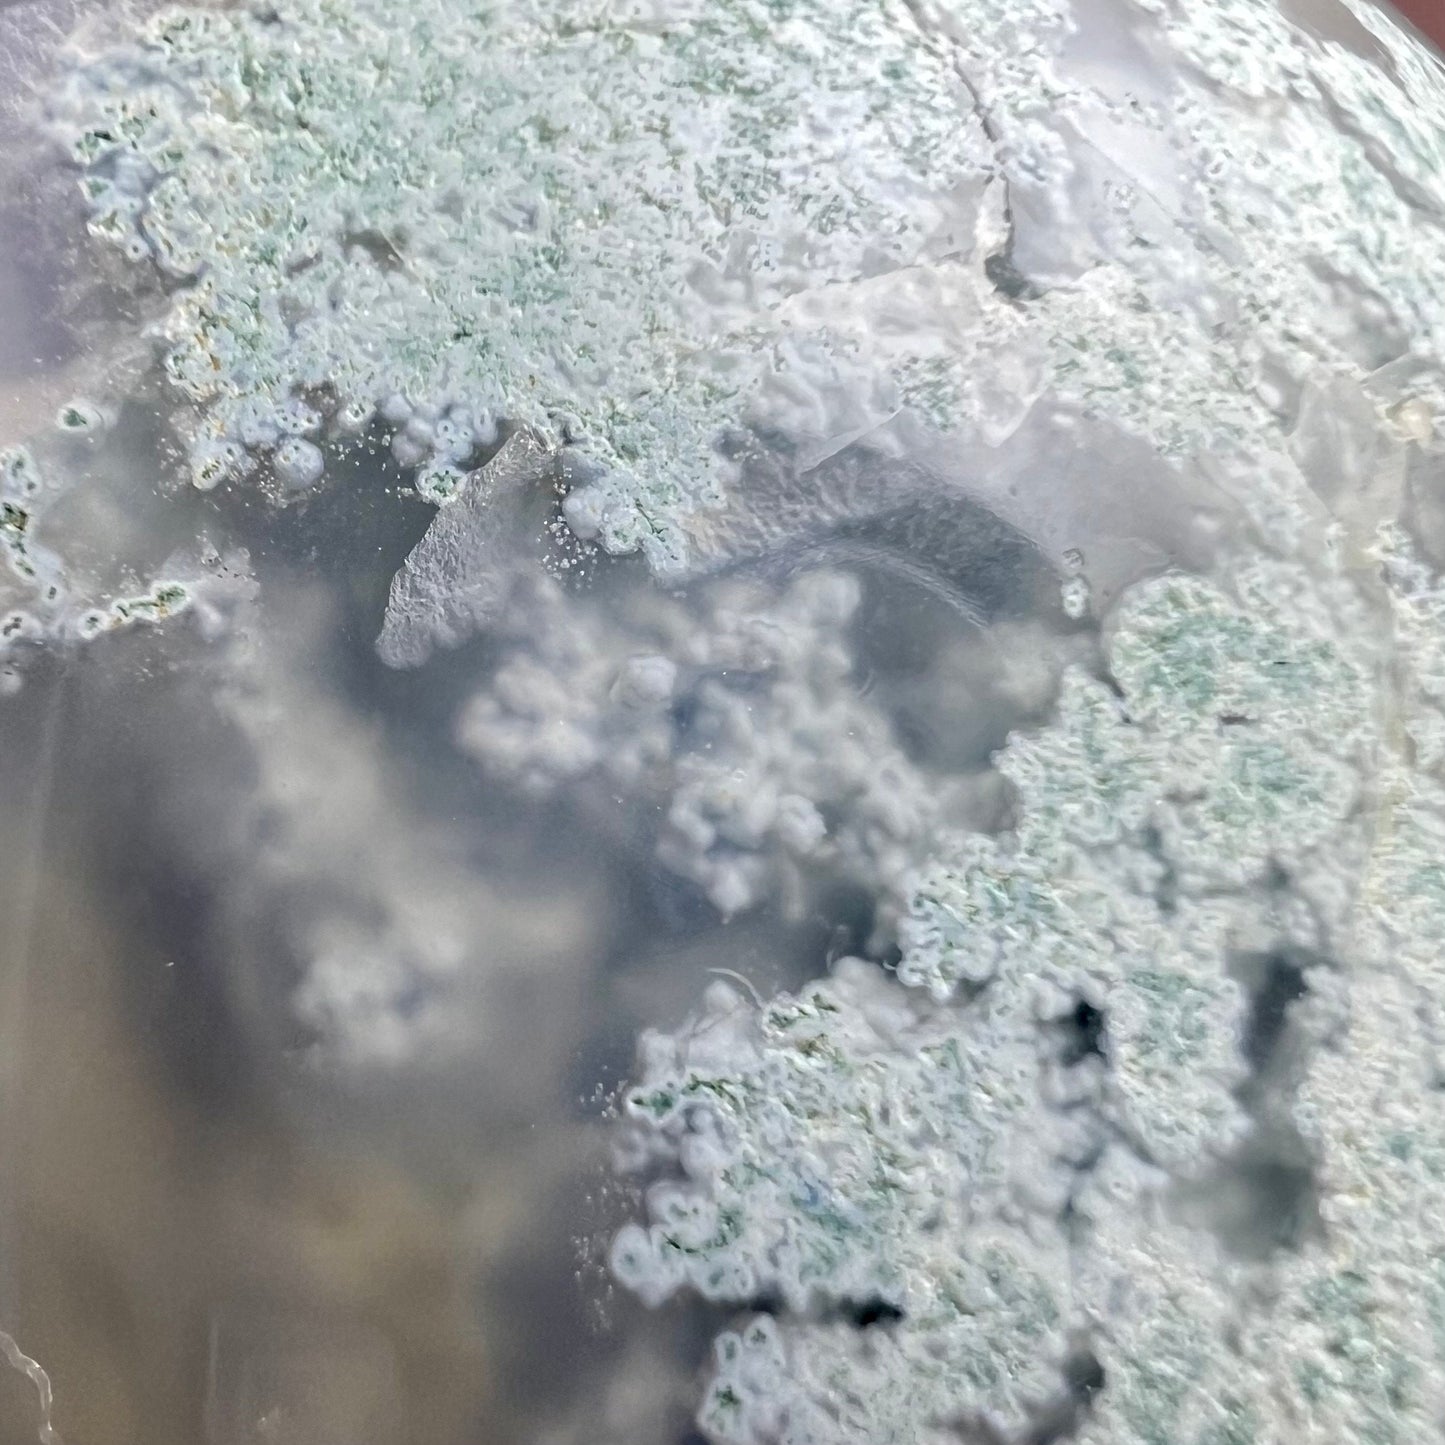
Unique Moss Agate Sphere | Druzy Moss Agate

Unique Moss Agate Sphere | Druzy Moss Agate
Unique Moss Agate Sphere | Druzy Moss Agate
Couldn't load pickup availability
Gorgeous moss agate sphere with unique colors, great translucency, and a small quartz druzy pocket. Basic sphere stand included.
Diameter: 2.68”/68.19 mm
0.89 lbs/14.24 oz
Disclaimer: Crystals are natural products the earth and are not always “perfect”. Some may have surface marks, inclusions, vugs (cavities) and/or natural chips. Also, many carvings are hand carved and may not be as pristine as a machine carved piece.
We do our best to ensure our crystals are photographed to show all angles, but occasionally, smaller natural marks may not show up correctly or be photographed up close. Please feel free to reach out before purchasing if you want to see anything in more detail.
We will always disclose damage that is not natural i.e. a broken crystal. If a crystal arrives broken, please reach out and we can help with initiating a claim, when applicable.